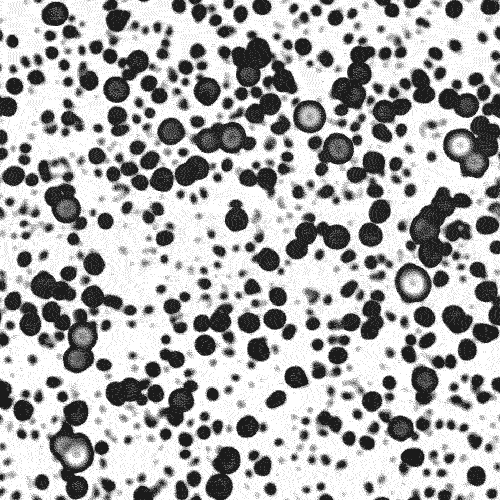
Slide 2 of 22

1 / 22
GPU Reaction Diffusion Simulation
These GIFs were created by simulating Gray-Scott's model of reaction-diffusion on a 2D grid. Reaction-diffusion systems are extensively studied because they are believed to be linked to the chemical and biological processes responsible for natural pattern formation, such as zebra stripes or leopard spots. Additionally, when simulated and visualized, reaction-diffusion systems produce captivating and dynamic motion. The GIFs above showcase various growth patterns and oscillations observed in these systems.
In simple terms, reaction-diffusion systems model how one or more substances (e.g., gases or liquids) interact and change when mixed in a contained environment. The reaction aspect describes the chemical interactions between the substances, potentially resulting in the creation of new compounds. The diffusion aspect defines how these substances spread throughout the container. If you're interested in learning more, check out my Instructable on 3D Printed Reaction Diffusion Patterns.
Credits
Designer & Developer: Reza Ali
Output: GIFs & Custom Software (C++, openFrameworks)
Year: 2014